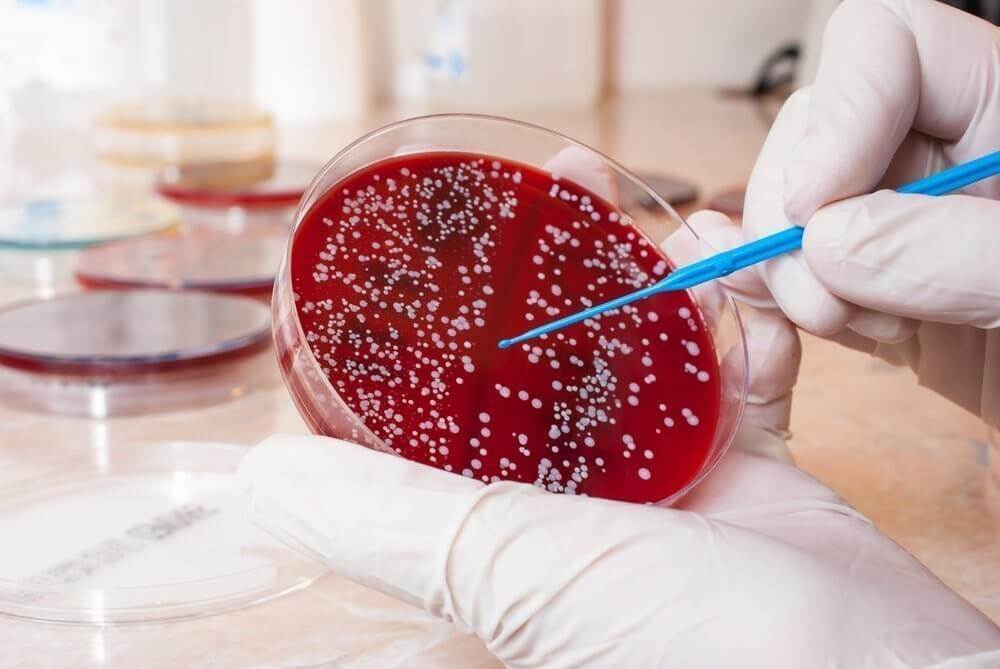
image

Тонзиллофарингит — воспаление миндалин и глотки, возникающее у взрослых и детей. Это состояние может быть вызвано вирусными и бактериальными инфекциями, что требует тщательной диагностики и лечения. В статье рассмотрим основные причины, симптомы и методы лечения тонзиллофарингита, а также рекомендации по профилактике, чтобы помочь читателям своевременно обращаться за медицинской помощью.
Диагностика острого тонзиллофарингита
При наличии симптомов стрептококковой инфекции диагноз подтверждается положительным микробиологическим тестом (экспресс-тестом на антиген БГСА или мазком из зева). Тест следует провести до начала антибактериальной терапии, так как даже одна доза антибиотиков может привести к ложному отрицательному результату.
Экспресс-тесты на БГСА имеют специфичность более 95% и чувствительность от 70 до 90%. Положительный результат теста достаточно для диагностики стрептококкового фарингита, однако отрицательный не исключает наличие инфекции. Если у ребенка или подростка тест отрицательный, необходимо провести мазок из зева. При положительном результате экспресс-теста дальнейшее бактериологическое исследование не требуется.
У взрослых при отрицательном результате экспресс-теста дополнительное микробиологическое исследование обычно не требуется.
Исследование на БГСА рекомендуется в следующих случаях:
- наличие признаков острого тонзиллофарингита (эритема, отек и/или экссудат в миндалинах) или скарлатинозной сыпи без симптомов вирусной инфекции;
- контакт с больным, у которого подтверждена стрептококковая инфекция (в домашних условиях или в школе);
- подозрение на острую ревматическую лихорадку или постстрептококковый гломерулонефрит.
Исследование на БГСА не рекомендуется детям и подросткам с признаками вирусной инфекции. От 5 до 21% детей в возрасте от 3 до 15 лет являются носителями БГСА, что может быть ошибочно интерпретировано как стрептококковый фарингит.
Своевременное лечение БГСА у детей и подростков необходимо для:
- предотвращения гнойных осложнений и острой ревматической лихорадки;
- снижения риска передачи инфекции окружающим, особенно если пациент контактирует с человеком, у которого была острая ревматическая лихорадка;
- уменьшения продолжительности и тяжести симптомов заболевания.
Тонзиллофарингит распространен как среди взрослых, так и среди детей. Симптомы, такие как боль в горле, затрудненное глотание и повышение температуры, могут ухудшить качество жизни. Важно своевременно диагностировать и лечить заболевание, так как осложнения могут иметь серьезные последствия. Рекомендуются как консервативные методы (полоскания, противовоспалительные препараты), так и антибиотики при бактериальной природе заболевания. Профилактика, включая укрепление иммунной системы и соблюдение гигиенических норм, также важна для снижения заболеваемости. Пациенты должны не игнорировать симптомы и обращаться за медицинской помощью при первых признаках недуга.
Эксперты в области оториноларингологии отмечают, что тонзиллофарингит является распространённым заболеванием как у взрослых, так и у детей. В большинстве случаев его причиной становятся вирусные инфекции, однако бактериальные возбудители, такие как стрептококки, также могут играть значительную роль. Важно отметить, что симптомы заболевания могут варьироваться: у детей чаще наблюдаются высокая температура и выраженная боль в горле, тогда как у взрослых симптомы могут быть менее выраженными. Специалисты подчеркивают необходимость своевременной диагностики и лечения, чтобы избежать осложнений. В случае бактериальной инфекции может потребоваться антибиотикотерапия, тогда как вирусные формы часто лечатся симптоматически. Профилактика, включая соблюдение гигиенических норм и укрепление иммунной системы, также имеет большое значение для снижения заболеваемости.
https://youtube.com/watch?v=kxUkgG2uupA
Осложнения БГСА-фарингита
В большинстве случаев БГСА-фарингит проходит без осложнений. К негнойным осложнениям относятся острая ревматическая лихорадка, постстрептококковый гломерулонефрит, детские аутоиммунные нервно-психические расстройства, ассоциированные со стрептококковой инфекцией. Гнойные осложнения стрептококкового фарингита включают некротический фасцит, бактериемию.
Дифференциальный диагноз БГСА-фарингита включает как инфекционные, так и неинфекционные причины фарингита.
Основные вирусные заболевания, проявляющиеся острым фарингитом:
- инфекционный мононуклеоз — вирус Эпштейна-Барр (ВЭБ) и цитомегаловирус. Чаще встречается у подростков и характеризуется лихорадкой, тяжелым фарингитом (который длится дольше, чем БГСА-фарингит), передней и задней шейной или диффузной лимфаденопатией. Может присутствовать периорбитальный отек, легкая гепатомегалия и спленомегалия. У пациентов, которым назначен ампициллин, амоксициллин (иногда другие антибиотики) может появиться характерная сыпь;
- первичная ВИЧ-инфекция — может вызывать острый ретровирусный синдром (сходный с инфекционным мононуклеозом) у сексуально активных подростков или редко у детей, подвергшихся сексуальному насилию. Клинические признаки первичной ВИЧ-инфекции включают выраженную шейную или генерализованную лимфаденопатию и жалобы на лихорадку, потерю веса;
- вирус простого герпеса — фарингит, вызванный вирусом простого герпеса, проявляется пузырьковыми высыпаниями на слизистой оболочке, губах;
- грипп — характеризуется лихорадкой, кашлем, головной болью и миалгией, которые возникают при сезонных эпидемиях;
- другие вирусные заболевания — энтеровирусы, аденовирусы, риновирусы, коронавирусы, респираторно-синцитиальный вирус, вирусы парагриппа.
Основные бактериальные причины фарингита:
- стрептококки групп C и G — до сих пор существует дискуссия о роли этих бактерий в этиологии острого фарингита;
- neisseria gonorrhoeae (гонорея) — является относительно редкой причиной фарингита. Большинство случаев протекает бессимптомно или симптомы неспецифичны (например, гиперемия глотки, отек или экссудат в лакунах миндалин);
- fusobacterium necrophorum (синдром Лемьера) — является причиной большинства случаев гнойного тромбофлебита яремной вены. Клинические признаки включают острый фарингит, высокую температуру (39 °C), респираторные симптомы, односторонний отек шеи или боль;
- дифтерия — редко встречается в развитых странах, но важно учитывать у пациентов из эндемичных районов. В отличие от БГСА-фарингита, который имеет острое начало, нарастание симптомов дифтерии обычно происходит постепенно. Отличительной чертой дифтерии является образование серого пленчатого налета, плотно прилегающего к слизистой оболочке носа и горла, удаление которого приводит к кровотечению;
- другие — туляремия (Francisella tularensis), Arcanobacteium haemolyticum, Mycoplasma pneumoniae.
Неинфекционные причины фарингита диагностируются на основании истории заболевания. Это могут быть раздражение или сухость глотки, инородное тело (например, рыбья кость), химическое воздействие, иррадиирущие боли при абсцессе зубов, остром средним отите.
| Симптом | Взрослые | Дети |
|---|---|---|
| Боль в горле | Острая, может отдавать в уши | Острая, может быть трудно описать, может сопровождаться плачем и капризами |
| Температура | Может быть высокой (38-40°C), может быть и субфебрильной | Часто высокая (38-40°C) и выше |
| Озноб | Часто присутствует | Может быть выраженным, сопровождаться дрожью |
| Головная боль | Часто присутствует, может быть интенсивной | Может быть, часто сопровождается раздражительностью |
| Слабость, недомогание | Выражены | Выражены, могут проявляться в виде апатии, сонливости |
| Кашель | Может быть сухим или влажным, обычно умеренный | Может быть сухим, лающим, или влажным, часто интенсивный |
| Насморк | Может быть, часто умеренный | Может быть, часто обильный |
| Затрудненное глотание | Может быть выражено | Может быть выражено, ребенок может отказываться от еды |
| Отек миндалин | Может быть выражен, с гнойными пробками или без | Может быть выражен, часто с гнойными пробками |
| Высыпания | Редко | Возможно появление сыпи при вирусной этиологии |
| Осложнения | Абсцесс, отит, ревматизм | Абсцесс, отит, ревматизм, дегидратация |
Интересные факты
Вот несколько интересных фактов о тонзиллофарингите у взрослых и детей:
-
Разнообразие причин: Тонзиллофарингит может быть вызван как вирусами (например, аденовирусами, вирусами гриппа), так и бактериями (чаще всего стрептококками группы A). У детей вирусные инфекции составляют большую часть случаев, тогда как у взрослых бактериальные инфекции могут встречаться чаще.
-
Симптомы и диагностика: У детей тонзиллофарингит часто проявляется более ярко, с выраженной болью в горле, высокой температурой и увеличением лимфатических узлов. У взрослых симптомы могут быть менее выраженными, что иногда затрудняет диагностику и приводит к запоздалому лечению.
-
Роль иммунной системы: У детей тонзиллофарингит может быть связан с незрелостью иммунной системы, что делает их более уязвимыми к инфекциям. С возрастом иммунная система становится более эффективной, но у взрослых также могут возникать рецидивы тонзиллофарингита, особенно при наличии хронических заболеваний или ослаблении иммунитета.
https://youtube.com/watch?v=LuBTchg_4pM
Лечение острого тонзиллофарингита
Антибактериальная терапия показана пациентам с симптомами фарингита или тонзиллофарингита при положительных результатах экспресс-теста на антиген или культуры на стрептококк группы А. Эмпирическое лечение не рекомендуется, так как клинические проявления фарингита, вызванного бета-гемолитическим стрептококком группы А, и нестрептококкового фарингита пересекаются. Небольшие задержки в начале терапии (например, в ожидании результатов посева) не увеличивают риск осложнений, включая острую ревматическую лихорадку. Однако влияние таких задержек на вероятность других осложнений, например, перитонзиллярного абсцесса, неясно. При высокой вероятности бета-гемолитического стрептококкового фарингита и отсутствии быстрых результатов тестирования целесообразно начать антибиотикотерапию. Если диагноз не подтверждается, антибиотики следует отменить.
Лечение антибиотиками не рекомендуется для бессимптомных хронических носителей бета-гемолитического стрептококка группы А или для носителей с признаками острого вирусного фарингита.
Тонзиллофарингит — это воспаление миндалин и глотки, которое может затрагивать как взрослых, так и детей. У детей заболевание проявляется ярче: высокая температура, боль в горле и затрудненное глотание. Важно своевременно обратиться к врачу, чтобы избежать осложнений. Взрослые переносят тонзиллофарингит легче, но также испытывают дискомфорт и усталость. Люди делятся опытом использования различных средств: от полоскания солевыми растворами до противовирусных препаратов. Профилактика включает соблюдение гигиенических норм и укрепление иммунной системы. Индивидуальный подход к каждому случаю способствует более быстрому выздоровлению и снижению риска рецидивов.
Антибактериальная терапия
Препаратом выбора для лечения БГСА-фарингита являются антибиотики пенициллинового ряда. Пенициллин — единственный антибиотик, который был изучен и показал снижение частоты развития острой ревматической лихорадки. Для полноценной эрадикации БГСА длительность курса антибактериальной терапии составляет 10 дней.
Амоксициллин более предпочтителен для детей младшего возраста. Его можно давать один раз в день, используя формы с пролонгированным высвобождением препарата (суспензии). В нескольких рандомизированных исследованиях амоксициллин в суспензии в стандартной дозе (один раз в день) показал такую же эффективность, как и пенициллин, принимавшийся перорально.
В случае аллергии к пенициллинам или плохой переносимости предпочтение отдается антибиотикам цефалоспоринового ряда, линкозамидам (клиндамицин) и макролидам — выбор препарата зависит от вида аллергической реакции на пенициллин.
Тетрациклины, сульфаниламиды и фторхинолоны не должны использоваться для лечения стрептококкового фарингита из-за высокой резистентности и высокого профиля побочных эффектов.
Для облегчения лихорадки и боли могут применяться нестероидные противовоспалительные препараты (ибупрофен) или ацетаминофен (парацетамол).
https://youtube.com/watch?v=T8xmPerdpwU
Общие рекомендации
Отдых, достаточное потребление жидкости, легкое питание и минимизация раздражителей дыхательных путей важны для восстановления. Большинство пациентов могут вернуться к обычной деятельности, будь то работа или учеба, после одного полного дня лечения, если общее состояние здоровья это позволяет.
Эта рекомендация основана на исследовании среди детей, которое показало, что около 80% пациентов с подтвержденным стрептококковым фарингитом становятся не заразными в течение 24 часов после начала лечения.
Контрольный экспресс-тест на стрептококк после завершения терапии обычно не требуется, за исключением следующих случаев:
- пациенты с историей острого ревматизма;
- пациенты, заболевшие во время вспышки острого ревматизма или постстрептококкового гломерулонефрита;
- пациенты, заразившиеся от близких родственников.
Если контрольный тест положительный, рекомендуется пройти повторный 10-дневный курс антибактериальной терапии с антибиотиком более высокой стабильности.
Профилактика острого тонзиллофарингита
Гигиена рук — ключевая мера предотвращения распространения инфекции. Руки следует мыть обязательно после эпизодов кашля или чихания, а также перед приготовлением пищи или еды.
Вакцинация — вакцина против БГСА пока не доступна. Тем не менее, исследования по ее разработке продолжаются.
Фарингит – воспалительное заболевание глотки, сопровождающееся отеком ее тканей и болью при глотании. Болезнь может иметь острое или хроническое течение. Лечение фарингита зависит от его причины и включает системную и локальную терапию.
Причины
Среди причин фарингита выделяют инфекционные и неинфекционные факторы.
- В 70% случаев симптомы фарингита вызваны вирусами: аденовирусом, риновирусом, коронавирусом, энтеровирусом, а также вирусами гриппа и парагриппа. Обычно заболевание проявляется в холодное время года, когда увеличивается заболеваемость ОРВИ.
- У 20% пациентов причиной становятся бактерии: гемофильная палочка, моракселла, возбудитель дифтерии, стрептококки, гонококки, микоплазмы и хламидии.
- Неинфекционные причины фарингита включают аллергические реакции, травмы, инородные тела в глотке, раздражающие пары и облучение.
- Воспаление глотки может быть спровоцировано курением, переохлаждением и чрезмерным употреблением алкоголя.
- Хроническая форма фарингита развивается на фоне синуситов, тонзиллита, кариеса, искривления носовой перегородки, аденоидов и других заболеваний носоглотки.
- Хронизация заболевания может быть связана с эндокринными расстройствами, заболеваниями желудка и кишечника, туберкулезом и ВИЧ.
Причина заболевания влияет на проявления и подходы к лечению фарингита.
Симптомы
Воспалительная реакция на попадание в слизистую оболочку глотки возбудителя вызывает такие симптомы фарингита:
- неприятные ощущения в горле: першение, саднение, боль, сухость и жжение;
- осиплость голоса, чувство заложенности ушей;
- усиление боли при глотании, ее иррадиация в уши, ощущение постороннего предмета или кома в горле.
Лихорадка для изолированного фарингита нехарактерна. Однако в тяжелых случаях, при стрептококковой природе заболевания, а также при поражении других ЛОР-органов возможно повышение температуры, увеличение шейных лимфоузлов.
Если болезнь вызвана вирусами, она может сопровождаться другими признаками ОРВИ – насморком, заложенностью носа, покраснением глаз, сухим кашлем или охриплостью голоса. У детей нередко присоединяется диарея.
При бактериальной природе болезни симптомы фарингита могут включать небольшой кашель с выделением светлой, а в запущенных случаях – гнойной мокроты. В этом случае у детей также не исключены боли в животе и жидкий стул.
Для хронического течения характерно постоянное затруднение глотания, сухость в горле, неприятный запах изо рта.
Симптомы, требующие срочной медицинской помощи:
- невозможность глотания воды и жидкой пищи;
- затрудненное, шумное дыхание через рот, удушье, обильное слюнотечение;
- сильная лихорадка, не поддающаяся лечению жаропонижающими средствами, особенно у маленьких детей при судорогах или нарушении сознания.
Виды
Острый фарингит обычно проявляется в катаральной форме, что указывает на его поверхностный характер. Гнойные варианты встречаются реже.
Существует несколько типов хронического фарингита:
- катаральный — длительное поверхностное воспаление, нарушение кровообращения, венозный застой и постоянная отечность тканей;
- гипертрофический — утолщение всех слоев стенки глотки и увеличение лимфоидных фолликулов;
- атрофический — уменьшение количества слизистых желез, истончение, сухость и повышенная уязвимость стенок глотки.
Методы лечения фарингита зависят от его типа: при остром воспалении назначают антимикробные и противовоспалительные средства, а при хроническом акцент делают на локальную терапию и физиотерапевтические процедуры для восстановления тканей глотки.
Диагностика
При фарингоскопии врач определяет такие объективные симптомы фарингита:
- покраснение и отек слизистой оболочки глотки;
- слизисто-гнойный налет на ее стенках;
- вовлечение в патологический процесс небных миндалин, дужек, устьев слуховых труб;
- ярко-красные бугорки на боковых и задней поверхности глотки – увеличенные лимфоидные фолликулы;
- при атрофическом фарингите видна истонченная блестящая слизистая с участками отслаивающегося эпителия, корок, вязкой слизи.
Единственным способом, позволяющим достоверно отличить вирусный фарингит от бактериального, является обнаружение стрептококков или других микроорганизмов в материале, полученном с задней стенки глотки. Это может быть микробиологическое исследование, в том числе с применением ПЦР-метода, или экспресс-тест. Лечение фарингита у взрослых и детей часто необоснованно начинают с антибиотиков, тогда как эти препараты следует использовать только при бактериальной форме болезни.
Лечение
Применяется лечение, направленное на выявление и устранение причин заболевания, блокирование его прогрессирования и облегчение симптомов.
Медикаменты
Если доказана бактериальная (стрептококковая) природа болезни, лечение фарингита обязательно включает антибиотики:
- фенокисметилпенициллин в таблетках, а при его непереносимости – препарат цефалоспоринов III поколения цефиксим;
- для уменьшения кратности приема пенициллина – амоксициллин в таблетках; однако его нельзя использовать при подозрении на инфекционный мононуклеоз;
- при непереносимости этих групп антибиотиков – джозамицин, реже другие макролиды или линкозамиды.
Длительность лечения фарингита антибиотиками составляет 10 дней, за исключением азитромицина, который принимается внутрь в течение 5 дней. При сохранении лихорадки через 2 – 3 дня приема антибиотика его заменяют на препарат другой группы.
Для антибиотикотерапии у детей удобны растворимые формы, например, Флемоклав Солютаб.
Если воспаление вызвано кандидозом, назначают противогрибковые препараты, а при аллергической реакции – антигистаминные средства.
Средства местного действия
При вирусном фарингите и для лечения бактериальных инфекций рекомендуются местные препараты:
- Антисептики: предотвращают размножение патогенных микроорганизмов и очищают слизистую носоглотки. К ним относятся Фарингосепт (таблетки для рассасывания), Антиангин-Формула (пастилки), Септолете нео (пастилки), растворы Вокадин и Мирамистин, аэрозоли Гексаспрей и Гексорал.
- Антибиотики для местного применения: Грамицидин С, Граммидин.
- Противовоспалительные и обезболивающие средства: Стрепсилс Интенсив, Тантум Верде.
- Растительные препараты: растворы Ромазулан (с ромашкой), Ротокан (с ромашкой, календулой и тысячелистником), Эвкалимин (с эвкалиптом).
- Стимуляторы местного иммунитета: Имудон.
Некоторые средства содержат несколько активных компонентов:
- Ангидин: два антисептика и витамин С;
- Анти-Ангин: обезболивающее, антисептик, витамин С и ментол;
- Гексализ: обезболивающее, противовоспалительное и антисептик;
- Дрилл: обезболивающее и антисептик;
- Ингалипт: антимикробное средство, антисептик и эфирные масла;
- Каметон: камфора, ментол, эвкалиптовое масло и антисептик;
- Нео-ангин: обезболивающее, охлаждающее и антисептическое;
- Пропосол: прополис, глицерин и этанол;
- Себидин: антисептик и витамин С;
- Септогал и Септолете: ментол, антисептик и эфирные масла.
Выбор средств следует согласовать с врачом. Препараты с хлоргексидином не подходят для детей, а растительные компоненты могут вызвать аллергические реакции.
Лечение в домашних условиях
Часто лечение фарингита не требует длительного приема каких-либо медикаментов. В легких случаях достаточно применять домашние средства:
- диета, включающая теплые протертые блюда и большое количество жидкости;
- горячие ванночки для ног с горчичным порошком;
- употребление теплого молока с медом;
- полоскание горла раствором соли, соды, фурацилина, настоями ромашки, эвкалипта, тысячелистника, календулы;
- паровые ингаляции с щелочной минеральной водой или содовым раствором;
- отказ от курения.
При атрофическом фарингите полезно смазывание горла персиковым маслом, глицерином, раствором Люголя, полоскание раствором поваренной соли с добавлением йода.
Физиотерапия
При фарингите терапия взрослых и детей включает физиотерапевтические методы. Эти процедуры применяются в восстановительный период после острого заболевания или в стадии ремиссии хронического фарингита. Врач может назначить электрофорез с калия йодидом, УВЧ-терапию, ультразвуковые процедуры, а также аппликации парафина или озокерита на область под челюстью.
Для лечения гипертрофического гранулезного хронического фарингита эффективны лазеротерапия и радиоволновая дезинтеграция, которые разрушают гранулезную ткань на задней стенке глотки.
Также рекомендуется лечение на бальнеологических и морских курортах, что положительно сказывается на состоянии пациента.
Хирургическое лечение
Операции выполняются для устранения причин фарингита, а также при сопутствующих ЛОР-заболеваниях, ухудшающих его течение. Проводятся:
- коррекция носовой перегородки, удаление аденоидов и полипов носоглотки;
- удаление небных миндалин (тонзилэктомия) при сопутствующем хроническом тонзиллите;
- хирургическое лечение хронического синусита.
Возможные осложнения и прогноз
Фарингит легко лечится и редко вызывает серьезные осложнения. Прогноз для вирусного фарингита положительный — заболевание обычно заканчивается полным выздоровлением.
Если причиной является стрептококк, возможны осложнения, такие как эндокардит или гломерулонефрит. При распространении инфекции на близлежащие ткани существует риск заглоточного абсцесса.
Если воспаление глотки связано с другим заболеванием (например, ВИЧ, кандидозом, рефлюкс-эзофагитом), оно может сохраняться даже при лечении, пока не будет устранена основная причина.
Профилактика
Соблюдение личной гигиены помогает предотвратить большинство случаев фарингита. Чтобы избежать этого заболевания, следует:
- пользоваться только индивидуальной посудой, бутылкой с питьевой водой;
- избегать контактов с больными ОРЗ;
- чаще мыть руки, особенно перед едой и после кашля или чихания;
- дезинфицировать руки спиртосодержащими салфетками, если нет условий для их мытья водой с мылом;
- избегать курения и вдыхания табачного дыма.
Различия в проявлениях тонзиллофарингита у взрослых и детей
Тонзиллофарингит – это воспалительное заболевание, которое затрагивает миндалины (тонзиллы) и глотку (фаринкс). Хотя это заболевание может проявляться как у взрослых, так и у детей, его симптомы, течение и подходы к лечению могут значительно различаться в зависимости от возраста пациента.
У детей тонзиллофарингит чаще всего проявляется остро, с ярко выраженными симптомами. Основные признаки включают:
- Боль в горле: Дети могут жаловаться на сильную боль при глотании, что может привести к отказу от еды и питья.
- Повышенная температура: У детей температура может подниматься до 39-40 градусов Цельсия, что требует внимательного наблюдения.
- Общее недомогание: Дети могут быть капризными, уставшими и менее активными, чем обычно.
- Увеличение лимфатических узлов: Часто наблюдается увеличение шейных лимфатических узлов, что может быть болезненным при пальпации.
- Кашель и насморк: Эти симптомы могут также присутствовать, особенно если тонзиллофарингит вызван вирусной инфекцией.
У взрослых проявления тонзиллофарингита могут быть менее выраженными, но также могут включать:
- Боль в горле: Хотя боль может быть сильной, у взрослых она часто менее интенсивна, чем у детей.
- Температура: У взрослых температура может быть менее высокой, иногда достигая лишь 38 градусов Цельсия.
- Общее состояние: Взрослые могут испытывать усталость и недомогание, однако это может быть менее заметно из-за привычного ритма жизни.
- Симптомы, связанные с работой дыхательных путей: У взрослых может наблюдаться более выраженный кашель и заложенность носа, особенно если заболевание вызвано вирусами.
Важно отметить, что у детей тонзиллофарингит может протекать с более высоким риском развития осложнений, таких как абсцесс миндалин или острый средний отит. У взрослых, особенно у тех, кто имеет сопутствующие заболевания или ослабленный иммунитет, также могут возникнуть серьезные осложнения, такие как пневмония или инфекция крови.
Лечение тонзиллофарингита у детей и взрослых также может различаться. У детей предпочтение отдается симптоматической терапии, включая жаропонижающие и обезболивающие средства, в то время как у взрослых может быть назначено более агрессивное лечение, включая антибиотики, если заболевание имеет бактериальную природу.
Таким образом, различия в проявлениях тонзиллофарингита у взрослых и детей требуют индивидуального подхода к диагностике и лечению, что подчеркивает важность консультации с врачом при появлении симптомов заболевания.
Вопрос-ответ
Как быстро вылечить тонзиллофарингит?
Препаратом выбора для лечения БГСА-фарингита являются антибиотики пенициллинового ряда. Пенициллин — единственный антибиотик, который был изучен и показал снижение частоты развития острой ревматической лихорадки. Для полноценной эрадикации БГСА длительность курса антибактериальной терапии составляет 10 дней.
Чем отличается тонзиллит от тонзиллофарингита?
Тонзиллит представляет собой воспаление небных миндалин (гланд), которые являются частью иммунной системы и служат для защиты организма от инфекций. В свою очередь, фарингит — это воспаление слизистой оболочки глотки, обычно затрагивающее заднюю стенку глотки.
В каком возрасте болеют тонзиллитом?
Наиболее часто болезнь возникает у детей 5-10 лет, однако может развиваться и в более старшем или младшем возрасте. Тонзиллит имеет инфекционную природу, то есть возникает при попадании в детский организм бактерий, вирусов и (реже) грибков.
Советы
СОВЕТ №1
Обратите внимание на симптомы. При первых признаках тонзиллофарингита, таких как боль в горле, затрудненное глотание или увеличение лимфатических узлов, не откладывайте визит к врачу. Раннее обращение за медицинской помощью поможет избежать осложнений и ускорит процесс выздоровления.
СОВЕТ №2
Следите за режимом питья. Увлажнение организма играет важную роль в процессе выздоровления. Пейте достаточно жидкости, чтобы смягчить горло и предотвратить обезвоживание. Теплые напитки, такие как травяные чаи или бульоны, могут быть особенно полезны.
СОВЕТ №3
Не забывайте о домашнем уходе. Полоскания солевым раствором или раствором соды могут помочь уменьшить воспаление и облегчить боль в горле. Также полезно использовать увлажнители воздуха, чтобы поддерживать оптимальный уровень влажности в помещении.
СОВЕТ №4
Следите за своим питанием. Включите в рацион легкие и питательные продукты, такие как супы, пюре и йогурты. Избегайте острых и кислых блюд, которые могут раздражать горло. Правильное питание поможет вашему организму быстрее восстановиться.